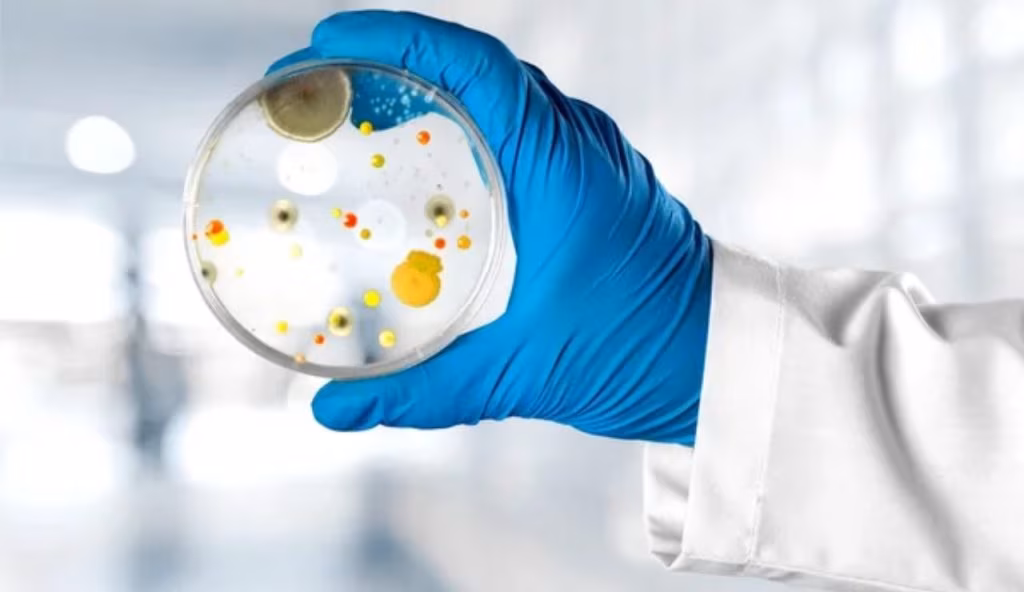

Scatta l’allerta in tutti gli ospedali: un batterio sta infettando tutti i pazienti | Riesce ad attaccarsi ad ogni cosa che trova
Allarme Batteri (Depositphotos foto) - www.biomedicalcue.it
Una nuova allerta è stata diramata riguardo una possibile infezione batterica che si può contrarre in ospedale.
Le infezioni batteriche rappresentano una delle principali minacce per la salute umana da secoli. Causate da microrganismi invisibili a occhio nudo, i batteri possono attaccare diversi organi e sistemi del corpo, provocando malattie che vanno da semplici mal di gola a infezioni gravi come la polmonite, la meningite o la sepsi.
Fortunatamente, la scoperta degli antibiotici nel XX secolo ha rivoluzionato la medicina, rendendo curabili molte infezioni che in passato erano spesso mortali. Tuttavia, il problema non è stato risolto una volta per tutte. L’uso eccessivo o scorretto degli antibiotici ha favorito la comparsa di ceppi batterici resistenti, contro cui i farmaci tradizionali non funzionano più.
Questo fenomeno, chiamato antibiotico-resistenza, è oggi una delle emergenze sanitarie più gravi a livello mondiale, secondo l’Organizzazione Mondiale della Sanità. Per contrastarlo, è fondamentale usare gli antibiotici solo quando necessario, seguendo sempre le indicazioni mediche, e investire nella ricerca di nuovi trattamenti.
La prevenzione, però, gioca un ruolo altrettanto importante: lavarsi frequentemente le mani, cucinare correttamente i cibi, curare l’igiene degli ambienti e vaccinarsi contro certe infezioni può ridurre drasticamente la diffusione di batteri patogeni. Anche l’educazione sanitaria nelle scuole e nelle comunità è cruciale per rendere le persone consapevoli e responsabili.
Un nemico invisibile
In conclusione, le infezioni batteriche sono un nemico invisibile ma concreto, che richiede attenzione, prevenzione e rispetto delle regole mediche. Solo così possiamo continuare a difenderci efficacemente da queste malattie, proteggendo non solo la nostra salute individuale, ma anche quella collettiva.
Un aspetto importante da considerare è la capacità dei batteri di adattarsi e sopravvivere in ambienti ostili, grazie alla loro rapidità di mutazione. Questo li rende particolarmente difficili da combattere, soprattutto negli ospedali, dove i pazienti sono più vulnerabili e l’uso frequente di antibiotici crea condizioni favorevoli per la diffusione di ceppi resistenti, come lo Staphylococcus aureus o la Klebsiella pneumoniae multiresistente.

Allarme negli ospedali
Un recente studio della Brunel University di Londra ha rivelato che un ceppo di Pseudomonas aeruginosa, un batterio ospedaliero noto per la sua resistenza agli antibiotici, possiede un enzima capace di degradare la plastica. Questo scoperta è significativa perché, oltre a utilizzare la plastica come fonte di nutrimento, il batterio impiega i prodotti della sua degradazione per rafforzare la matrice protettiva dei biofilm, aggregazioni batteriche estremamente resistenti che rendono le infezioni difficili da trattare.
La presenza di plastica sterile in ospedali — come guanti, cerotti, cateteri e siringhe — potrebbe quindi favorire la sopravvivenza e la diffusione di Pseudomonas aeruginosa. Questo “appetito per la plastica” potrebbe spiegare in parte perché questo patogeno sia così diffuso e difficile da eliminare negli ambienti sanitari.